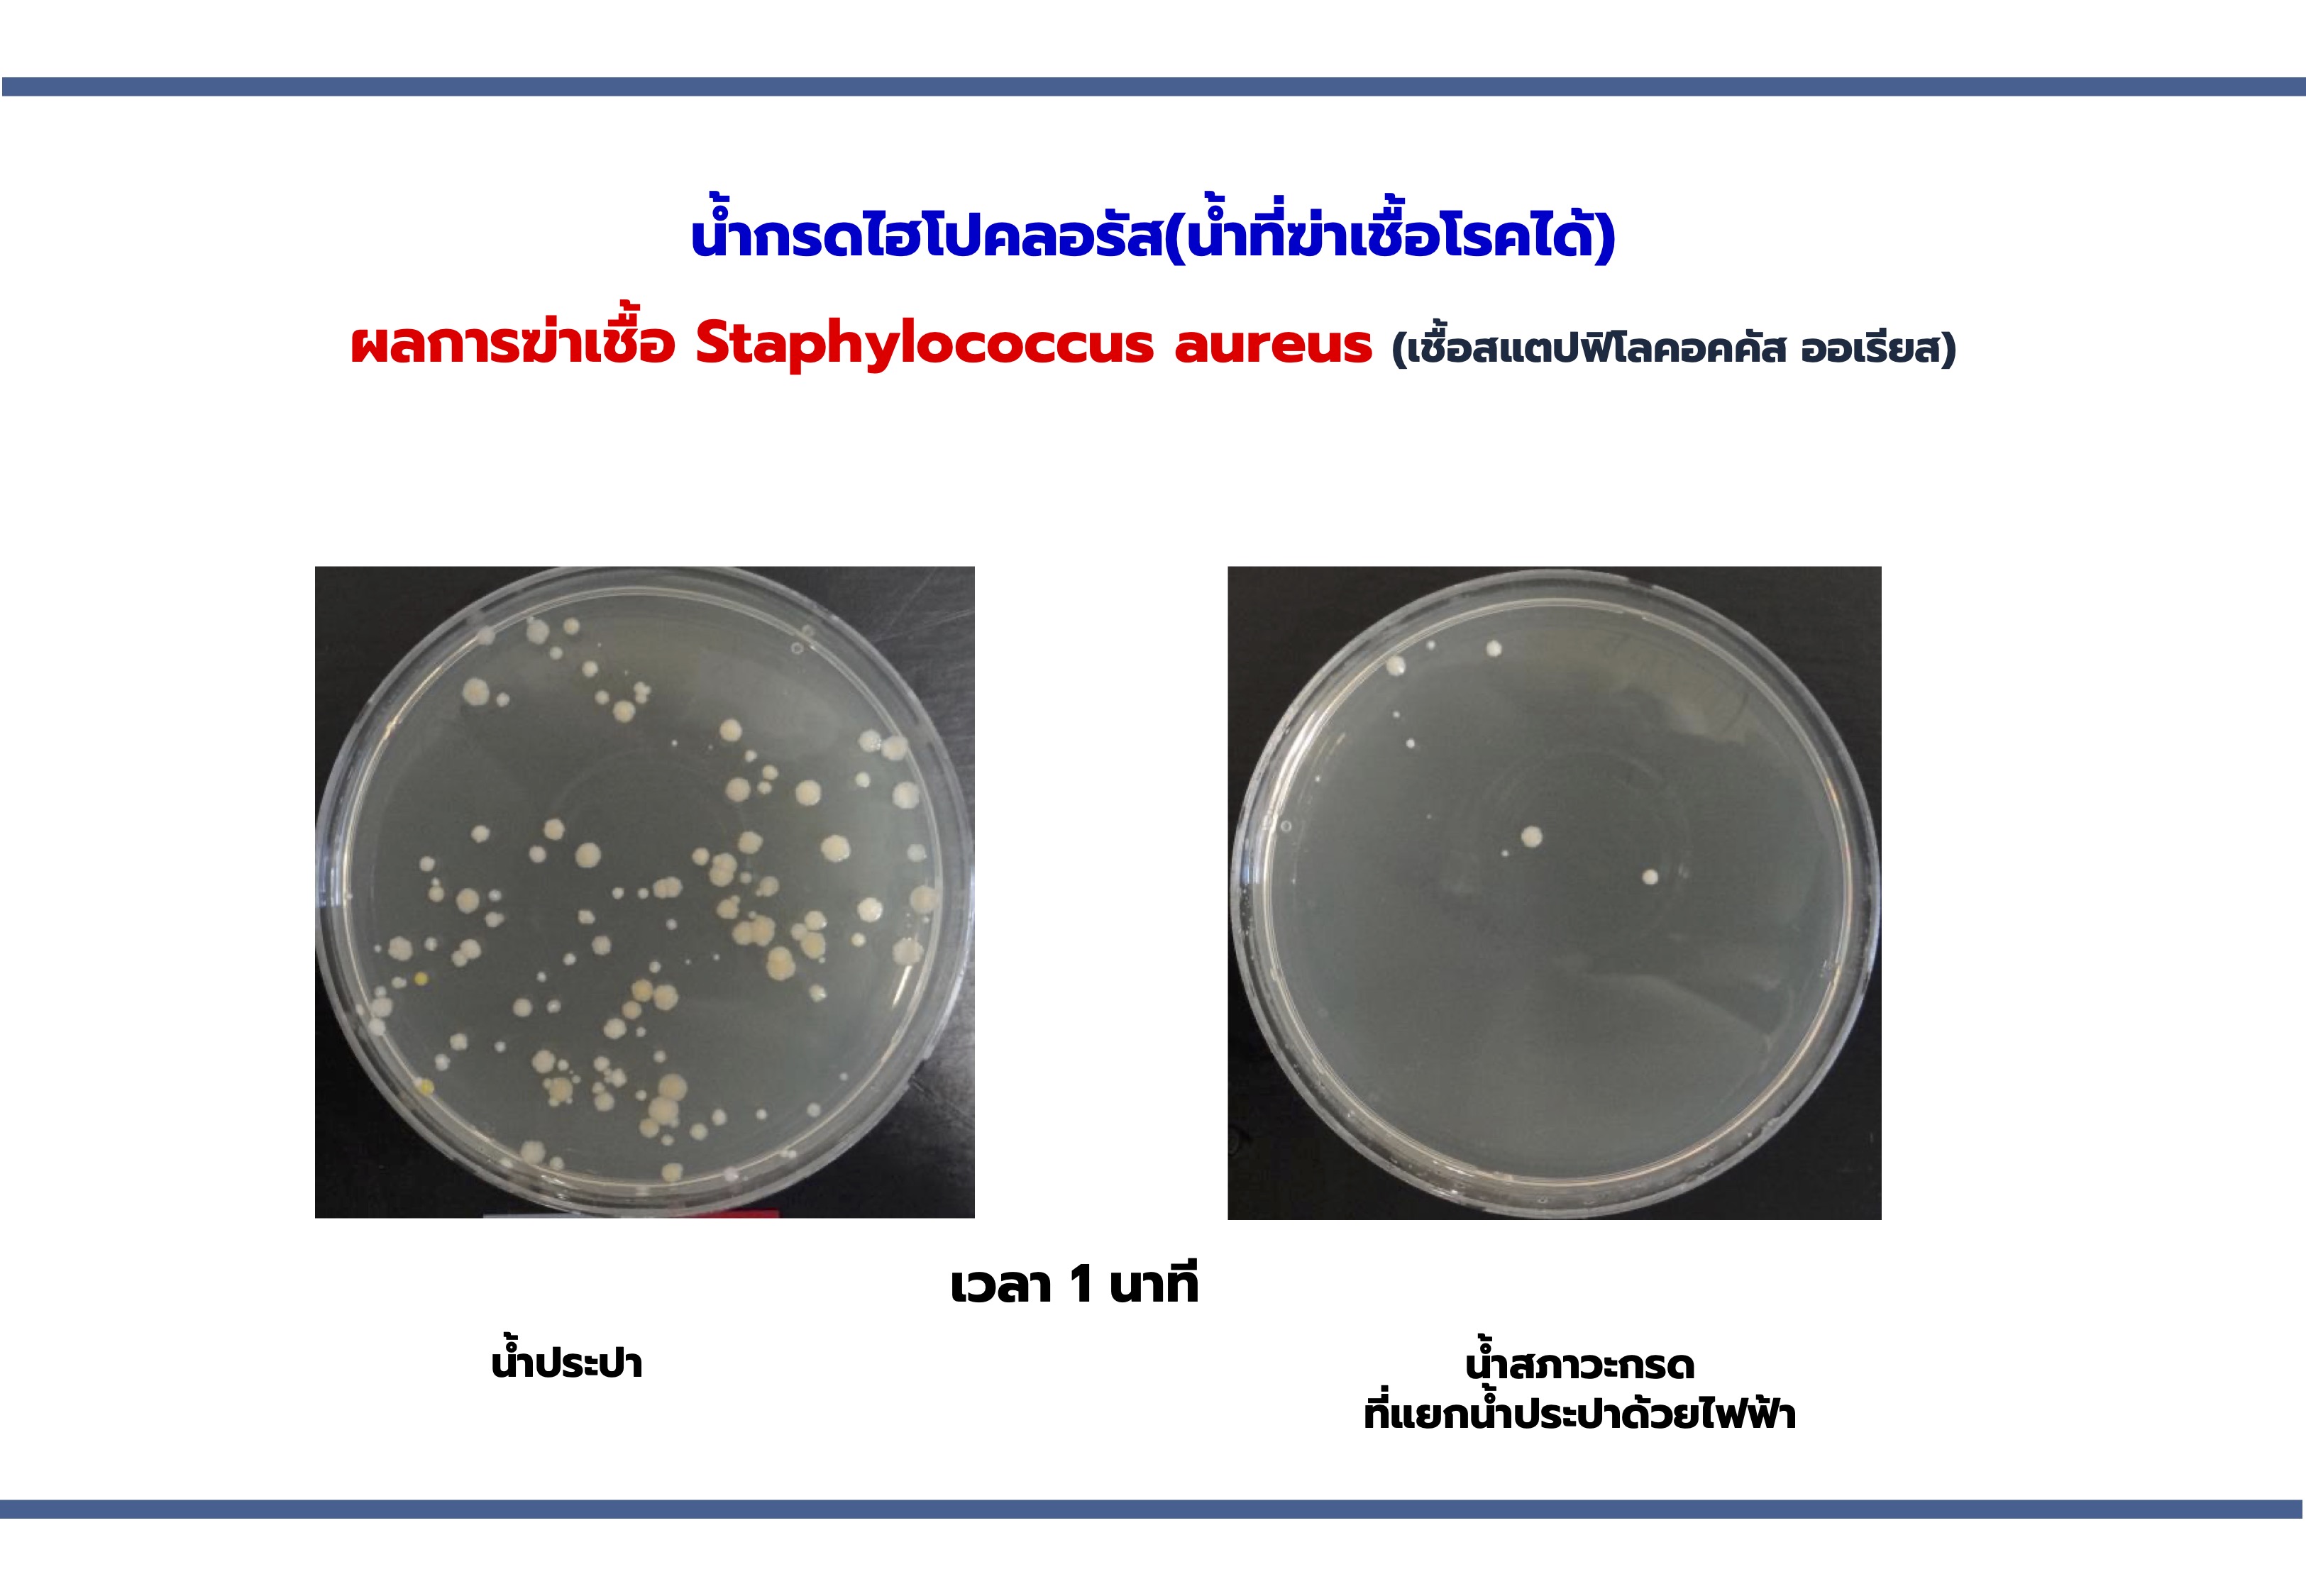
Alkaline Healing Water (EOS)-เครื่องกรองน้ำอัลคาไลน์ ไฮโดรเจน

Alkaline Healing Water (EOS)
เครื่องกรองน้ำอัลคาไลน์+ไฮโดรเจน
ผลิตอย่างใส่ใจ มีคุณภาพ นำเข้าจากประเทศเกาหลี
เหตุผลที่คุณควรดื่มน้ำอัลคาไลน์+ไฮโดรเจน
... ปัจจัยต่างๆ เช่น อาหาร, ความเครียด, และกิจวัตรประจำวัน มักทำให้ร่างกายอยู่ในสภาวะความเป็นกรด ส่งผลให้เซลล์เสื่อมโทรม อ่อนเพลีย แก่ชราเร็ว และเสี่ยงต่อการเกิดโรคต่างๆ การดื่มน้ำอัลคาไลน์ช่วยปรับสมดุลความเป็นกรด-ด่างในร่างกาย ทำให้เซลล์แข็งแรง มีพลังงานดี ส่งผลให้ร่างกายป้องกันโรคได้ดีขึ้น และรู้สึกสดชื่น กระปรี้กระเปร่า
คุณสมบัติเด่น ที่คุณจะได้รับ
1. ระบบกรองน้ำอัลคาไลน์ พิเศษ!! เครื่องนี้สามารถปรับระดับค่า pH ของน้ำได้ตั้งแต่ pH 3.5 (กรด) ถึง pH 10 (ด่าง) ให้คุณเลือกใช้น้ำที่เหมาะสมตามความต้องการ อย่างหลากหลายตามการใช้งานจริง
... 1.1 Acid (กรด) : เหมาะสำหรับการล้างหน้า แปรงฟัน อาบน้ำ ทำความสะอาด และซักล้าง
... 1.2 Pure (กลาง/ธรรมชาติ) : เหมาะสำหรับเด็กเล็กและผู้ป่วยโรคไต น้ำที่เป็นกลางช่วยลดความเสี่ยงต่อร่างกายจากการดื่มน้ำที่มีค่า pH สูงหรือต่ำเกินไป
... 1.3 Alkaline (ด่าง) pH 8.5 - 10
- pH 8.5 - 9.0 : เหมาะสำหรับดื่มน้ำประจำวัน ช่วยปรับสมดุลกรดในร่างกาย
- pH 9.5 : เหมาะสำหรับชงเครื่องดื่ม เช่น ชา กาแฟ เพื่อเพิ่มรสชาติและความนุ่มนวล และลดความเป็นกรดจากคาเฟอีน
- pH 10 : เหมาะสำหรับทำอาหาร ทำให้อาหารเกิดความเป็นกลางมากขึ้น รวมทั้งใช้ล้างผัก-ผลไม้ จะช่วยล้างสารเคมีตกค้างได้อย่างมีประสิทธิภาพ
2. ระบบไฮโดรเจน : ช่วยกำจัดอนุมูลอิสระที่เป็นสาเหตุของโรคหลายชนิด เช่น โรคมะเร็ง โรคหัวใจ ช่วยชะลอความแก่ และเสริมสร้างสุขภาพที่ดี ป้องกันการเกิดโรคไต ฟื้นฟูพลังงาน และยังช่วยควบคุมและลดน้ำหนักได้ด้วยเมื่อทานอย่างต่อเนื่อง(ควบคู่การคุมอาหารอย่างเหมาะสม)
3. ครอบคลุมการใช้งานทุกด้าน : ไม่ว่าจะใช้สำหรับดื่มน้ำเพื่อสุขภาพ ทำอาหาร หรือทำความสะอาด น้ำจากเครื่อง EOS จะช่วยให้คุณได้คุณภาพน้ำที่เหมาะสม ครอบคลุมทุกการใช้งานในชีวิตประจำวัน